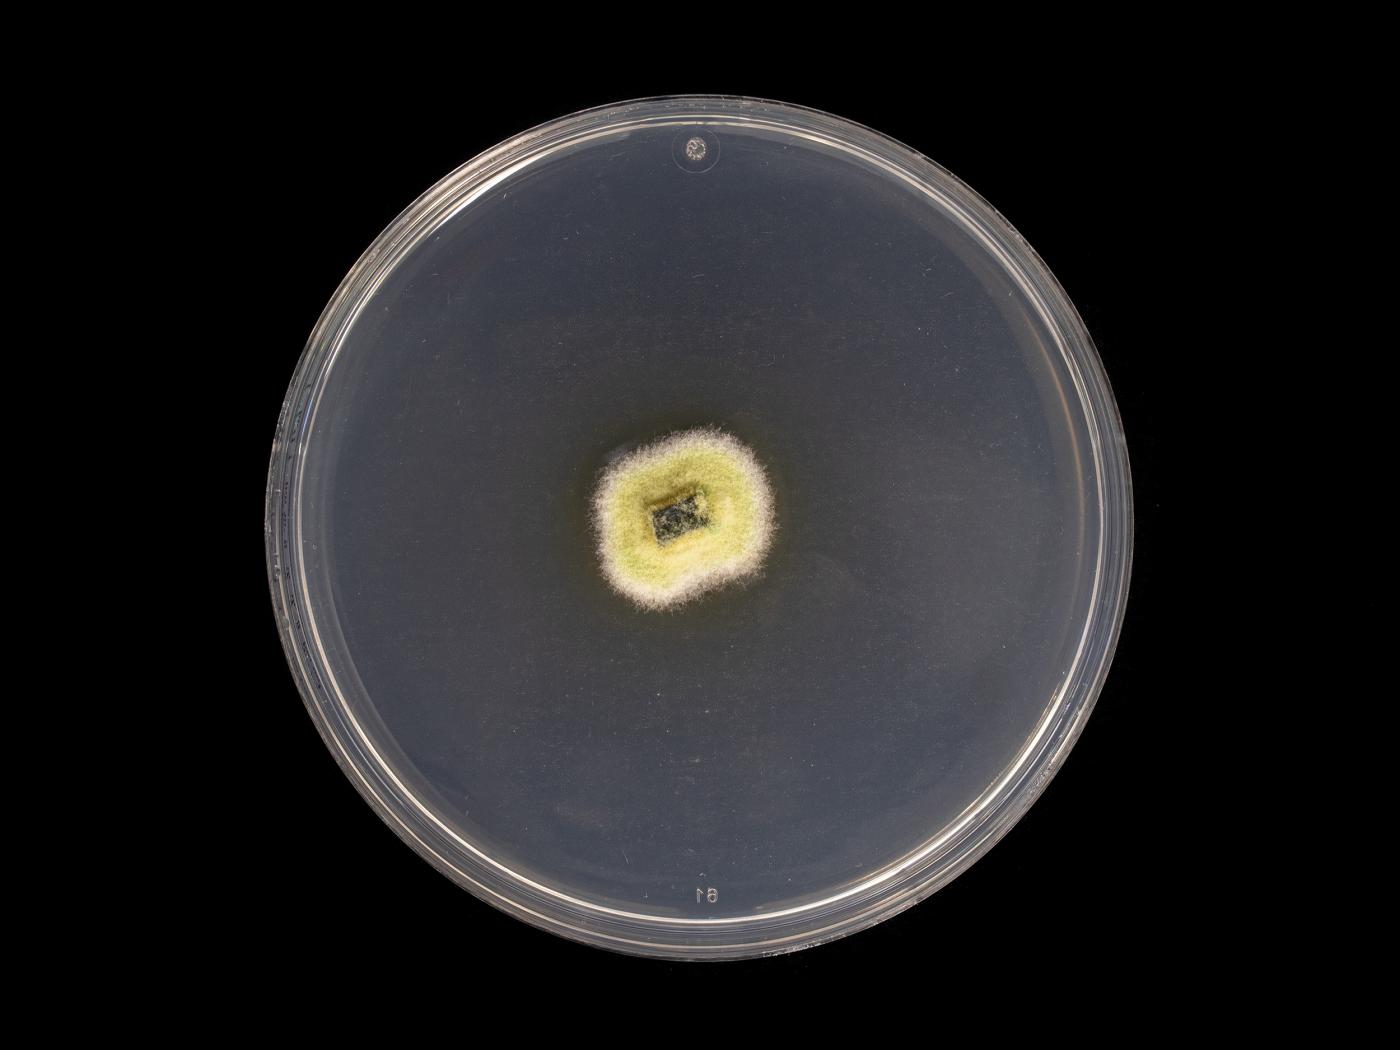

Nom latin :
Godronia cassandrae
Nom latin synonyme :
Fusicoccum putrefaciens,Godronia cassandrae f. vaccinii
Taxonomie : Règne : Fungi > Division : Ascomycota > Classe : Leotiomycetes > Ordre : Helotiales > Famille : Godroniaceae
Cultures ou autres organismes affectés
Bleuet en corymbe
/fr/maladies-parasitaires/champignons/godronia-cassandrae/bleuet-en-corymbe-chancre-fusicoccum
Bleuet en corymbe - Chancre à Fusicoccum (Godronia cassandrae)_1
Bleuet en corymbe - Chancre à Fusicoccum (Godronia cassandrae)_2
Bleuet en corymbe - Chancre à Fusicoccum (Godronia cassandrae)_3
Bleuet en corymbe - Chancre à Fusicoccum (Godronia cassandrae)_4
Bleuet en corymbe - Chancre à Fusicoccum (Godronia cassandrae)_5
Bleuet en corymbe - Chancre à Fusicoccum (Godronia cassandrae)_2
Bleuet en corymbe - Chancre à Fusicoccum (Godronia cassandrae)_3
Bleuet en corymbe - Chancre à Fusicoccum (Godronia cassandrae)_4
Bleuet en corymbe - Chancre à Fusicoccum (Godronia cassandrae)_5